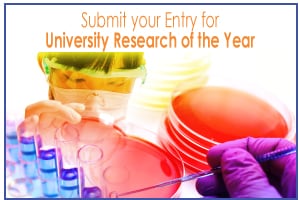
NIAw17-Entries-University.jpg

The review describes how the use of a piglet model, coupled with advanced analytical techniques, provide deeper insights into early-life nutrition and neurodevelopment questions.
In addition, the research team detail the use of new nutritional targets in optimising nutritional profiles for the developing brain.
The work also takes into account the emerging discoveries garnered from the gut-brain axis. Here, the piglet model could prove beneficial in explaining how nutrition affects this connection.
“We know from human work that different brain regions mature at different rates. So you may not see an effect of dietary intervention in the whole-brain, but if you were to look at specific brain regions at different time points you might see a dietary effect,” explained Austin Mudd, a doctoral student at the University of Illinois.
“We should be looking at individual brain regions in a dietary intervention study, rather than assessing the brain as one unit. From there, we can start to identify optimal windows in which developing brain regions are differentially sensitive to nutrition."
Infant formula insights

Along with co-study author Ryan Dilger, an animal scientist at the university, Mudd also detailed findings from previous research that describes the effects of fatty acids in human breast milk or infant formula.
Human milk is generally thought of as a point of reference for early-life nutrition.
As a result of nutritional differences between infant formula and human milk,differences have been noted in brain maturation and function between breastfed and formula-fed infants.
Therefore ongoing interest exists, particularly by infant formula makers, in defining the components of human milk that contribute to optimal brain development, which can be included into standard infant diets.
“Research has highlighted the need to understand ways in which altered ratios and different sources of fatty acids might affect bioavailability in the developing neonate,” the study commented.
Other aspects of milk composition reviewed include choline, iron, cholesterol, amino acids, milk fat globule membranes, and other milk bioactives, including sialic acid, gangliosides, and alpha-lipoic acid.
Here the team deduced that from its roles in the body's nervous systems, it was possible that taking in the breast milk bioactive protein lactoferrin, might promote development of the gut-brain axis.
Pediatric nutrition research regularly focuses on development of the gastrointestinal tract, as this system is crucial to ensuring continued growth.
The review also emphasised the importance of assessing combinations of dietary compounds as a way of more accurately representing the way bioactive components are received by infants.
NutraIngredients Awards 2017
University Research of the Year
Healthy foods, supplements, nutrients are built on sound research. Has your team been pushing the nutritional research envelope?
Submit your entry for University Research of the Year
The team outlined a selection of studies that stressed the importance of highlighting the novelty of the bioactive compounds being tested, while also focusing on the sensitivity of the brain to their presence.
“It is increasingly apparent that higher amounts of one compound may not always confer better neurodevelopment, thereby suggesting the importance of defining optimal amounts at which specific compounds should be incorporated into the diets used in future studies,” the study stated.
Micronutrient deficiencies
Deficiencies in micronutrients such as folate, iron, copper, and zinc, and the implications in infant neurodevelopment were also discussed in which the researchers emphasised that proper maternal nutrition was as important as adequate postnatal nutrition for ensuring optimal neurodevelopment.
Referring to the piglet model, the team thought that assessing piglet brain development in the context of micronutrient deficiencies, the ‘mechanisms that underlined the decreased childhood cognition observed in human studies could corroborate previous findings of altered structural brain development.’
Mudd and Dilger also detailed the latest analytical methods used to evaluate brain development, outlining relevant areas for future nutrition and neurodevelopment research.
The technologies included magnetic resonance imaging (MRI) methods that can compare grey or white matter tissue volumes (Voxel-based morphometry), define absolute or relative volumes for distinct brain regions (Volumetric analysis) and the characterisation of microscopic water movements within the brain, which can help to monitor changes in neuron size (Diffusion tensor imaging).
Source: Advances in Nutrition
Published online ahead of print: doi:10.3945/an.116.013243
“Early-Life Nutrition and Neurodevelopment: Use of the Piglet as a Translational Model.”
Authors: Austin Mudd and Ryan Dilger